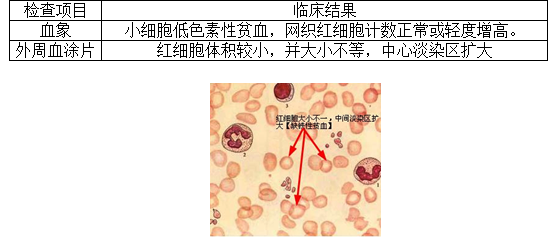

2020臨床執(zhí)業(yè)醫(yī)師考點(diǎn)-鐵代謝的實(shí)驗(yàn)室檢查【附經(jīng)典例題】
鐵代謝的實(shí)驗(yàn)室檢查是2020年臨床執(zhí)業(yè)醫(yī)師考試中血液系統(tǒng)會(huì)涉及到的考點(diǎn),醫(yī)學(xué)教育網(wǎng)編輯為大家整理如下:
【經(jīng)典例題】診斷缺鐵性貧血早期的實(shí)驗(yàn)室依據(jù)是
A.血清鐵降低
B.血清鐵蛋白降低
C.血清總鐵結(jié)合力增高
D.外周血呈小細(xì)胞低色素性貧血
E.骨髓象紅細(xì)胞胞漿成熟落后于胞核
『正確答案』B
『答案解析』診斷缺鐵性貧血早期主要血清鐵蛋白降低。
【經(jīng)典例題】女,30歲。乏力、頭暈伴月經(jīng)過多半年?;?yàn):Hb60g/L,RBC3.1×1012/L,WBC7.3×109/L,紅細(xì)胞中心淡染區(qū)擴(kuò)大。該患者最可能的化驗(yàn)結(jié)果是
A.血清鐵降低,總鐵結(jié)合力降低,紅細(xì)胞游離原卟啉降低
B.血清鐵降低,總鐵結(jié)合力降低,紅細(xì)胞游離原卟啉增高
C.血清鐵降低,總鐵結(jié)合力增高,紅細(xì)胞游離原卟啉增高
D.血清鐵增高,總鐵結(jié)合力增高,紅細(xì)胞游離原卟啉降低
E.血清鐵降低,總統(tǒng)結(jié)合力增高,紅細(xì)胞游離原卟啉降低
『正確答案』C
『答案解析』患者慢性失血,血象小細(xì)胞低色素貧血,考慮是缺鐵性貧血,總鐵結(jié)合力增高和紅細(xì)胞游離原卟啉增高,其他都是降低的。
以上關(guān)于“2020臨床執(zhí)業(yè)醫(yī)師考點(diǎn)-鐵代謝的實(shí)驗(yàn)室檢查【附經(jīng)典例題】”的文章由醫(yī)學(xué)教育網(wǎng)編輯整理搜集,希望可以幫助到大家,更多的文章隨時(shí)關(guān)注醫(yī)學(xué)教育網(wǎng)臨床執(zhí)業(yè)醫(yī)師輔導(dǎo)精華欄目!
〖醫(yī)學(xué)教育網(wǎng)版權(quán)所有,轉(zhuǎn)載必究〗

- · 臨床醫(yī)師實(shí)踐技能第一站病例分析歷年考點(diǎn)題:營養(yǎng)性維生素D缺乏性佝僂病
- · 2021年臨床執(zhí)業(yè)醫(yī)師實(shí)踐技能病例分析試題(營養(yǎng)性維生素D缺乏性佝僂?。?/a>
- · 臨床執(zhí)業(yè)醫(yī)師筆試考試兒科學(xué)“缺鐵性貧血臨床表現(xiàn)”知識(shí)點(diǎn)
- · 臨床執(zhí)業(yè)醫(yī)師血液系統(tǒng)《鐵代謝》5大考點(diǎn)精講!
- · 2020臨床執(zhí)業(yè)醫(yī)師考點(diǎn)-鐵代謝的實(shí)驗(yàn)室檢查【附經(jīng)典例題】

掃一掃立即下載


